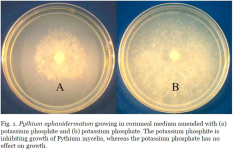
Abb-1-Direkte-Wirkung-von-Kaliumphosphit-auf-Pythium.png Abb-1-Direkte-Wirkung-von-Kaliumphosphit-auf-Pythium.png

GnosisOfAllogenes
Rising Star
Hello all.
I am posting in regards to my venerable San Pedros, who as some number of members may or may nor remember have survived multiple goat attacks, who have contracted some kind of horrific fungus. Pictures attached for examples of pathology. Here are my questions for cactus-cultivators: A) Do you happen to know what this fungal assailant is? It begins as a rust-colored patch of discoloration beneath the skin, then progresses to this white, scar-like material which then develops these tiny black spots over a period of time. Also B) from my research, the prognosis isn't really good. I think I need to cull the crop and start again from all the unaffected pups I have removed from the mother-cactus -- so my REAL question is this --- think if I made this mess into a standard tea that I'd be including nasty toxins from the fungus? Should I just attempt an extraction, as yielding semi-pure mescaline would remove some or lots (or all?) of any potential fungal toxins?
Here's the story:
I've had these growing since late 2010/early 2011, and have multiplied my cacti several times now as I always had a "thing" about harvesting with intent to eat my cultivated clones... I always felt like they were still too scrappy, they need to thicken up, they're too little, etc. I basically just didn't eat them, and living in a non-native climate where it gets to zero F/ -32 C many years in the winter I have to bring them in so they wont freeze. Well, then it got to the point that I was way cluttered up with cuttings on cuttings on cuttings (I still am, for the most part). Anyway, a temporary move to another city saw me transporting all of these cacti from the old spot to the new spot. I got all but the largest four specimens and left the four cacti in my dad's care.
Well, leaving it with my dad to care fore was just pure laziness on my part, and dang It appears I am paying for it now; he left them in a window just a bit too close to the woodstove... and there was some heat damage. By the time I found them, a few days of this cruel and inhumane punishment had already gone by.
I think it was these wounds that gave an opening to some opportunistic fungal attacker... because this horrible fungal scarring is occurring, well, all over. You all can see for yourselves, it's a horror show of bad Cactus-management skills.
edit - the examples attached here are all of the late stage of this thing. I've tried various fungicides, never was able to do anything more than slow its progress. However, with a solid feeding and anti fungal sprays new growth will outstrip the fungus, so I can salvage maybe the tips on a couple of these...
I'm worried about now introducing this pathogen into the clones that haven't been exposed yet.
I am posting in regards to my venerable San Pedros, who as some number of members may or may nor remember have survived multiple goat attacks, who have contracted some kind of horrific fungus. Pictures attached for examples of pathology. Here are my questions for cactus-cultivators: A) Do you happen to know what this fungal assailant is? It begins as a rust-colored patch of discoloration beneath the skin, then progresses to this white, scar-like material which then develops these tiny black spots over a period of time. Also B) from my research, the prognosis isn't really good. I think I need to cull the crop and start again from all the unaffected pups I have removed from the mother-cactus -- so my REAL question is this --- think if I made this mess into a standard tea that I'd be including nasty toxins from the fungus? Should I just attempt an extraction, as yielding semi-pure mescaline would remove some or lots (or all?) of any potential fungal toxins?
Here's the story:
I've had these growing since late 2010/early 2011, and have multiplied my cacti several times now as I always had a "thing" about harvesting with intent to eat my cultivated clones... I always felt like they were still too scrappy, they need to thicken up, they're too little, etc. I basically just didn't eat them, and living in a non-native climate where it gets to zero F/ -32 C many years in the winter I have to bring them in so they wont freeze. Well, then it got to the point that I was way cluttered up with cuttings on cuttings on cuttings (I still am, for the most part). Anyway, a temporary move to another city saw me transporting all of these cacti from the old spot to the new spot. I got all but the largest four specimens and left the four cacti in my dad's care.
Well, leaving it with my dad to care fore was just pure laziness on my part, and dang It appears I am paying for it now; he left them in a window just a bit too close to the woodstove... and there was some heat damage. By the time I found them, a few days of this cruel and inhumane punishment had already gone by.
I think it was these wounds that gave an opening to some opportunistic fungal attacker... because this horrible fungal scarring is occurring, well, all over. You all can see for yourselves, it's a horror show of bad Cactus-management skills.
edit - the examples attached here are all of the late stage of this thing. I've tried various fungicides, never was able to do anything more than slow its progress. However, with a solid feeding and anti fungal sprays new growth will outstrip the fungus, so I can salvage maybe the tips on a couple of these...
I'm worried about now introducing this pathogen into the clones that haven't been exposed yet.

) . I have half of my guys under a 1000 watt (I think) HPS light (which they seem to be enjoying); the other half I have in "dormant" phase in a room that honestly doesn't get adequate sunlight. So what do y'all think, in this indoor winter phase (which can last 3-5 months here), would utilizing a dehumidifier be a good call?
)